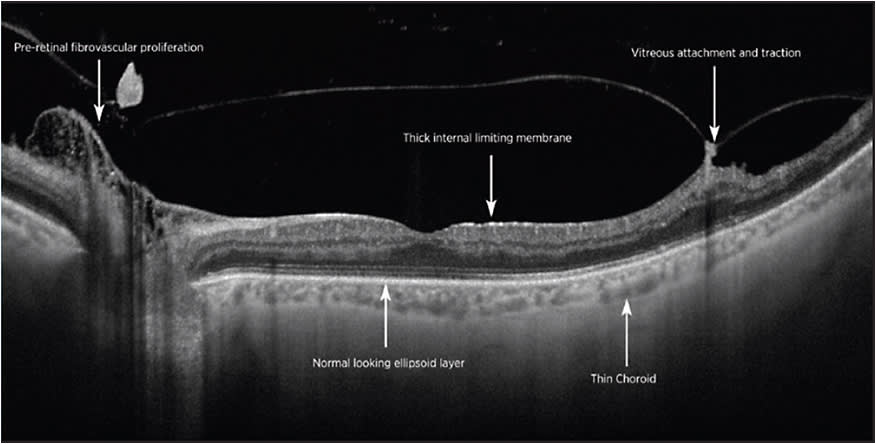
Figure 6. Swept Source OCT of proliferative diabetic retinopathy demonstrating details of fibrovascular proliferation and vitreous traction.
IMAGE COURTESY PROF. P.E. STANGA, MANCHESTER ROYAL EYE HOSPITAL, MANCHESTER VISION REGENERATION LAB AT NIRH, WELCOME TRUST MANCHESTER CRF, UNIVERSITY OF MANCHESTER, MANCHESTER, UK.
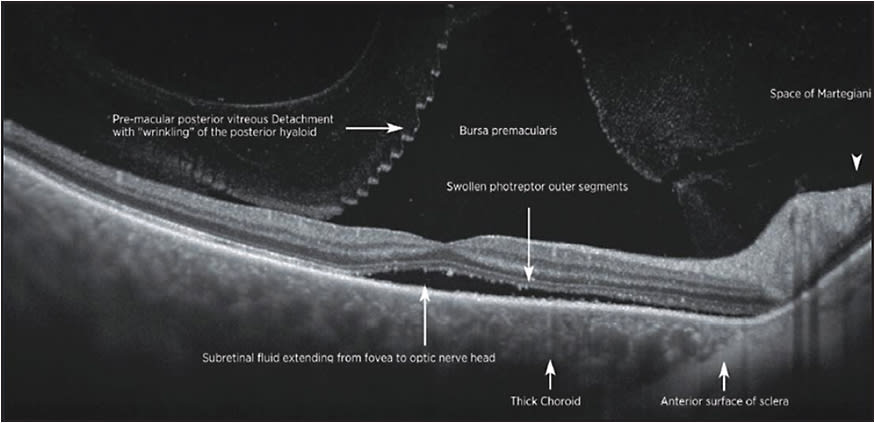
Figure 7. SS-OCT of CSR demonstrating details of vitreoretinal interface, retinal layers, and choroid.
IMAGE COURTESY PROF. P.E. STANGA, MANCHESTER ROYAL EYE HOSPITAL, MANCHESTER VISION REGENERATION LAB AT NIRH,  WELCOME TRUST MANCHESTER CRF, UNIVERSITY OF MANCHESTER, MANCHESTER, UK.

Optical coherence tomography (OCT) has revolutionized the diagnosis and management of retinal diseases. This noninvasive imaging technique produces high-resolution cross-sectional images of the retina, anterior segment, optic nerve head, and retinal nerve fiber layer, which resemble histological sections of the eye in vivo and is analogous to a “virtual optical biopsy.”
Until recently, detailed imaging analysis of the choroid was limited using spectral domain optical coherence tomography (SD-OCT) mostly because of decreased signal transmission through the retinal pigment epithelium (RPE) and light scatter caused by the dense vascular network of the choroid. Additionally, the wavelengths of light used had limited penetration into the depths of the choroid.
ENHANCED-DEPTH IMAGING
Enhanced-depth imaging (EDI) OCT modifies the standard technique of image acquisition to better reveal the structural details of the choroid. In 2008, Spaide et al1 described the technique of EDI-OCT, which moves the objective lens of the Spectralis SDOCT (SD-OCT) device closer to the eye, producing the inverted mirror image of the retina. This maneuver places the choroid closer to the zero delay line, increasing the signal depth. EDI-OCT has made choroidal imaging clearer with better definition all the way to the choroidal-scleral junction.
The choroid has the highest blood flow per unit weight of any tissue in the body, about 20 times to 30 times greater than that of the retina.2,3 The vasculature of the choroid supplies nutrients and oxygen to the retinal pigment epithelium, the outer retina, the avascular fovea and the prelaminar portion of the optic nerve.4 Because of its critical metabolic functions, the choroid is sensitive to systemic alterations in blood flow and plays a major role in disease states such as macular degeneration and cardiovascular-related changes. EDI-OCT has improved recognition of choroidal diseases such as age-related choroidal atrophy5 and choroidal thickening, referred to as the pachychoroid spectrum, which includes conditions such as central serous chorioretinopathy and polypoidal choroidal vasculopathy.
CENTRAL SEROUS CHORIORETINOPATHY
EDI-OCT demonstrated that patients with central serous chorioretinopathy (CSC) have a very thick choroid, which relates to increased choroidal vascular hyperpermeability and hydrostatic pressure changes.6 Enhanced-depth imaging OCT, has also revealed that in all eyes with CSC, besides a thickened subfoveal choroid, there is also a thinning of the inner choroidal layer and an enlargement of the underlying hyporeflective choroidal lumina. In addition, some eyes with CSC may demonstrate a dome-shaped RPE elevation, a double-layer sign of the RPE/Bruch membrane complex, and RPE microrips (Figure 1).7

AMD VS IPCV VS CSR
EDI-OCT can serve as a useful diagnostic tool to help differentiate between age-related macular degeneration (AMD) and idiopathic polypoidal choroidal vasculopathy (IPCV), which is associated with a thick choroid, whereas choroidal thinning is typical in eyes with AMD. In older patients, distinguishing between AMD, IPCV, and CSR can be challenging, and reliable choroidal thickness measurements using EDI-OCT are a useful diagnostic discriminator.8
Pigment epithelial detachments (PED) can often appear optically empty on conventional SD-OCT images, whereas with EDI-OCT, the contents of the PED can be better visualized.9 Using EDI-OCT, Spaide et al were able to demonstrate the choroidal neovascularization within the PED as a hyper-reflective layer of tissue under the back surface of the RPE (Figure 2).10

SWEPT-SOURCE OCT
Swept-source (SS) technology is another new approach to better image the choroid (DRI-OCT Triton; Topcon). It utilizes a longer 1,050 nm wavelength at a scanning speed of 100,000 A-scans/second. The faster scanning speed reduces artifacts due to eye movement, allowing more data with more detail to be collected. The longer wavelength is invisible, increasing patient comfort. Standard OCT utilizes wavelengths in the 800 nm to 870 nm range, with less penetration into the choroid. The longer wavelength reduces the scatter reflection of the RPE, enabling SS-OCT to show clearer details of the deeper portions of the choroid, and with increased patient comfort, it facilitates more stable fixation. The longer wavelength also penetrates more effectively through media opacities (Figure 3) and hemorrhage (Figure 4).11,12


Using the wide-field protocol, SS-OCT enables the disc and macula to be imaged in a single scan. This allows clinicians to assess the relationship of disease in the nerve and macula without having to look at separate scans taken with possibly different head positions and eye alignments (Figure 5). SS-OCT can show details of the vitreous, retina, and choroid simultaneously. SS-OCT can better highlight the vitreomacular interface (Figures 6, 7). Unlike with EDI-OCT that requires either the vitreous or the retina to be at focus, SS-OCT has a much larger depth of imaging that enables more detailed imaging of the vitreous.

The latest advancement of SS-OCT technology is the ability to generate OCT angiography. Its high-sensitivity imaging and deeper intravascular flow visualization can detect even low microvascular flow. This technology combines the advantages of OCT angiography with the SS-OCT such that multimodal image comparisons can be made to increase diagnostic capabilities (Figure 8).

In summary, EDI-OCT and SS-OCT provide exciting new windows into the choroid that can help with an array of diagnostic challenges. EDI-OCT is a standard feature of the capture software on all Spectralis systems (Heidelberg Engineering), and similar focusing strategies have been introduced by other manufacturers as well.
SS-OCT is still investigational, but it is available from Topcon and will soon be available from Zeiss. Its longer wavelength and faster speed provide deeper and wider access to the full range of ocular layers — vitreous, retina, choroid, sclera, and optic nerve — providing more detail and the opportunity for more accurate answers to clinical mysteries. RP
REFERENCES
- Spaide RF, Koisumi H, Posonni MC. Enhanced depth imaging spectral-domain optical coherence tomography. Am J Ophthalmol. 2008;146(4):496-500.
- Nickla DL, Wallman J. The multifunctional choroid. Prog Retin Eye Res. 2010;29(2):144-168.
- Mrejen S, Spaide RF. Optical coherence tomography: imaging of the choroid and beyond. Surv Ophthalmol. 2013;58(5):387-429.
- Hayreh SS. The blood supply of the optic nerve head and the evaluation of it—myth and reality. Prog Retina Eye Res. 2001;20(5):563-593.
- Margolis R, Spaide RF. A pilot study of enhanced depth imaging optical coherence tomography of the choroid in normal eyes. Am J Ophthalmol. 2009;147:811-815.
- Imamura Y, Fujiwara T, Margolis R, et al. Enhanced depth imaging optical coherence tomography of the choroid in central serous chorioretinopathy. Retina. 2009;29(10):1469-1473.
- Yang L, Jonas JB, Wei W. Optical coherence tomography-assisted enhanced depth imaging of central serous chorioretinopathy. Invest Opthalmol Vis Sci. 2013;57(7):4656-4665.
- Jirarattanasopa P, Ooto S, Nakata I, et al. Choroidal thickness, vascular hyperpermeability, and complement factor H in age-related macular degeneration and polypoidal choroidal vasculopathy. Invest Ophthalmol Vis Sci. 2012;53(7):3663-3672.
- Wong IY, Koizumi H, Lai WW. Enhanced depth imaging optical coherence tomography. Ophthalmic Surg Lasers Imaging. 2011;42 Suppl:S75-S84.
- Spaide RF. Enhanced depth imaging optical coherence tomography of retinal pigment epithelial detachment in age-related macular degeneration. Am J Ophthalmol. 2009;147(4):644-652.
- Hamzah F, Shinojima A, Mori R, Yuzawa M. Choroidal thickness measurement by enhanced depth imaging and swept-source optical coherence tomography in central serous chorioretinopathy. BMC Ophthalmol. 2014;14:145.
- Povazay B, Hermann B, Unterhuber A, et al. Three-dimensional optical coherence tomography at 1050 nm versus 800 nm in retinal pathologies: enhanced performance and choroidal penetration in cataract patients. J Biomed Opt. 2007;12(4):041211.








